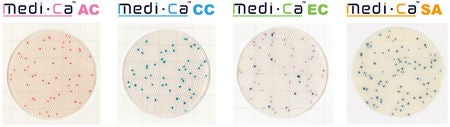

微生物検査用フィルム培地Medi・Ca(メディカ)シリーズ4種類すべてが国際的認証機関AOACのPTM認証を取得
2017年12月1日
大日本印刷株式会社(本社:東京 社長:北島義俊 資本金:1,144億円 以下:DNP)が開発した、「DNP微生物検査用フィルム培地 Medi・Ca®(メディカ)」シリーズの「黄色ブドウ球菌数測定用(SAグレード)」が、国際的に権威のある認証機関AOACのPTM(Performance Tested Methods:性能検証済み試験法)認証を取得しました。
Medi・Caシリーズは、食品・飲料メーカー等が行う品質管理用の微生物検査の効率を向上させるため、微生物を培養する培地にフィルムを使用した製品です。今回「黄色ブドウ球菌数測定用(SAグレード)」がPTM認証を取得したことで、「一般生菌数測定用(ACグレード)」、「大腸菌群数測定用(CCグレード)」、「大腸菌・大腸菌群数測定用(ECグレード)」に加えて、シリーズ4種全てが同認証を取得しました。従来の寒天培地を使ったシャーレでの微生物検査では、培地を調製する前処理作業などで熟練した作業者が必要でした。Medi・Caは、ゲル化剤や栄養成分などをシート状のフィルムにコーティングしており、この前処理作業が不要で、取り扱いが容易なため作業者の熟練も必要とせず、検査業務の効率化を実現します。

【AOACのPTM認証について】
国際的な認証機関であるAOACは、米国内の食品、医薬品、肥・飼料、化粧品等に関する新開発の検査法の妥当性検証を目的に設立されました。AOACのPTM認証は、AOACが認定した第3者機関で妥当性が確認された試験法であり、AOACの理念に基づいた厳しい検証の基準に合格した検査キットに与えられます。
【「DNP微生物検査用フィルム培地 Medi・Ca」の特長】
●簡単で扱いやすく、すぐに使える調製済み培地
外装袋から取り出してすぐに使用できるため、緊急の検査などにも迅速に対応できます。検査する食品・飲料などを希釈した試料液を培養エリアの中央に滴下し、カバーフィルムを閉じるだけで試料液が培養エリア全体に広がるため、効率的に作業を進めることができます。
●コロニーが見やすく、カウントしやすい
培養する菌に適した専用の発色剤を使用しているため、培養後の微小な菌の集合体(コロニー)の視認性が高く、食品残渣との判別も容易で、コロニー数の計測をスピーディかつ確実に行えます。
ACグレードはBacillus(バチルス)属菌によるコロニーの広がりが少ないことも特長です。
●省スペース化と廃棄量削減を実現
Medi・Caの容積は、従来の検査で使用するシャーレの約20分の1以下に減容化しているため、保管や培養に要するスペースを削減し、使用後の廃棄物量を削減します。また、滴下時にMedi・Caを重ねながら作業が行えるため、作業エリアの省スペース化も実現できます。
 左:シャーレ、右:Medi・Ca
左:シャーレ、右:Medi・Ca
【Medi・Caの製品ラインナップと価格(税抜き)】
一般生菌数測定用(ACグレード) | 各75,000円(1,000枚入) |
大腸菌群数測定用(CCグレード) | |
大腸菌・大腸菌群数測定用(ECグレード) | 47,500円(500枚入) |
黄色ブドウ球菌数測定用(SAグレード) | 75,000円(500枚入) |
【今後の展開】
今後DNPは、Medi・Caシリーズの4製品を食品・飲料・菓子メーカーや飲食チェーン店などを中心に販売し、2021年度に年間約3億円の売上を目指します。
- 「Medi・Ca」は、日本、タイ、中国、オーストラリアにおける大日本印刷株式会社の登録商標です。
- ニュースリリースに記載された製品の価格、仕様、サービス内容などは発表日現在のものです。その後予告なしに変更されることがありますので、あらかじめご了承下さい。
- 弊社「 DNP微生物検査用フィルム培地 Medi・ca」は、2021年3月31日をもちまして、キッコーマン株式会社に譲渡することになりました。2021年4月1日以降は譲渡した事業につきまして、キッコーマン株式会社のグループ会社であるキッコーマンバイオケミファ株式会社で「微生物検査用フィルム培地 Easy Plate」として引き続き販売されますので、ご愛顧のほどお願い致します。
